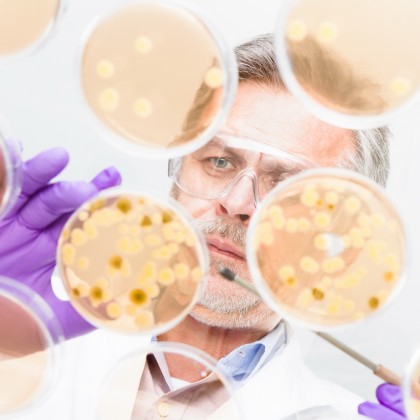
Antibiotice noi eficiente și fără risc de dezvoltare a rezistenței

Antibiotice noi eficiente și fără risc de dezvoltare a rezistenței
©
Autor: Vasiliu Alina
Cercetătorii de la Inserm și Université de Rennes au identificat recent o nouă toxină bacteriană pe care au transformat-o în antibiotice puternice active împotriva diferitelor bacterii responsabile de infecțiile umane, fie ele gram-pozitive sau negative.
Studiul s-a bazat pe sinteza de peptidomimetici, care au fost inspirați de peptidele bacteriene naturale existente, dar care au fost scurtate și modificate.
Din cele 20 de molecule create, două s-au dovedit eficiente împotriva bacteriilor Staphylococcus aureus și Pseudomonas aeruginosa la șoarecii cu sepsis sever sau infecție cutanată.
Acești compuși noi sunt bine tolerați de către organism și nu prezintă probleme de toxicitate renală.
Important de observat a fost faptul că bacteriile pe care cercetătorii le-au lăsat în contact timp de câteva zile cu aceste antibiotice nu au prezentat semne de rezistență.
Activitatea antibacteriană a acestor peptidomimetice se datorează parțial capacității aminoacizilor săi naturali de a reîntări asocierea acestor compuși cu membranele bacteriilor infecțioase. Această legătură duce la permeabilitatea membranei și la moartea bacteriilor.
Sursa: Science Daily
Peste 13000 de cabinete medicale își prezintă serviciile pe ROmedic.
Data actualizare: 19-07-2019 | creare: 19-07-2019 | Vizite: 854
Bibliografie
New antibiotics effective without triggering resistance, mouse study shows. Url: https://www.sciencedaily.com/releases/2019/07/190709141249.htm ©
Copyright ROmedic: Articolul se află sub protecția drepturilor de autor. Reproducerea, chiar și parțială, este interzisă!
Alte articole din aceeași secțiune:
- Oamenii de ştiință americani au creat nanoparticule care pot diminua infecțiozitatea virală a SARS-CoV-2
- Aplicație de mobil eficientă în ameliorarea incontinenței urinare
- Cel mai eficient tip de inteligență artificială în cercetarea medicală (studiu)
- FitSmoke – antrenorul personal pentru renunțarea la fumat
Din Biblioteca medicală vă mai recomandăm:
Din Ghidul de sănătate v-ar putea interesa și:
Forumul ROmedic - întrebări și răspunsuri medicale:
Pe forum găsiți peste 500.000 de întrebări și răspunsuri despre boli sau alte subiecte medicale. Aveți o întrebare? Primiți răspunsuri gratuite de la medici.intră pe forum